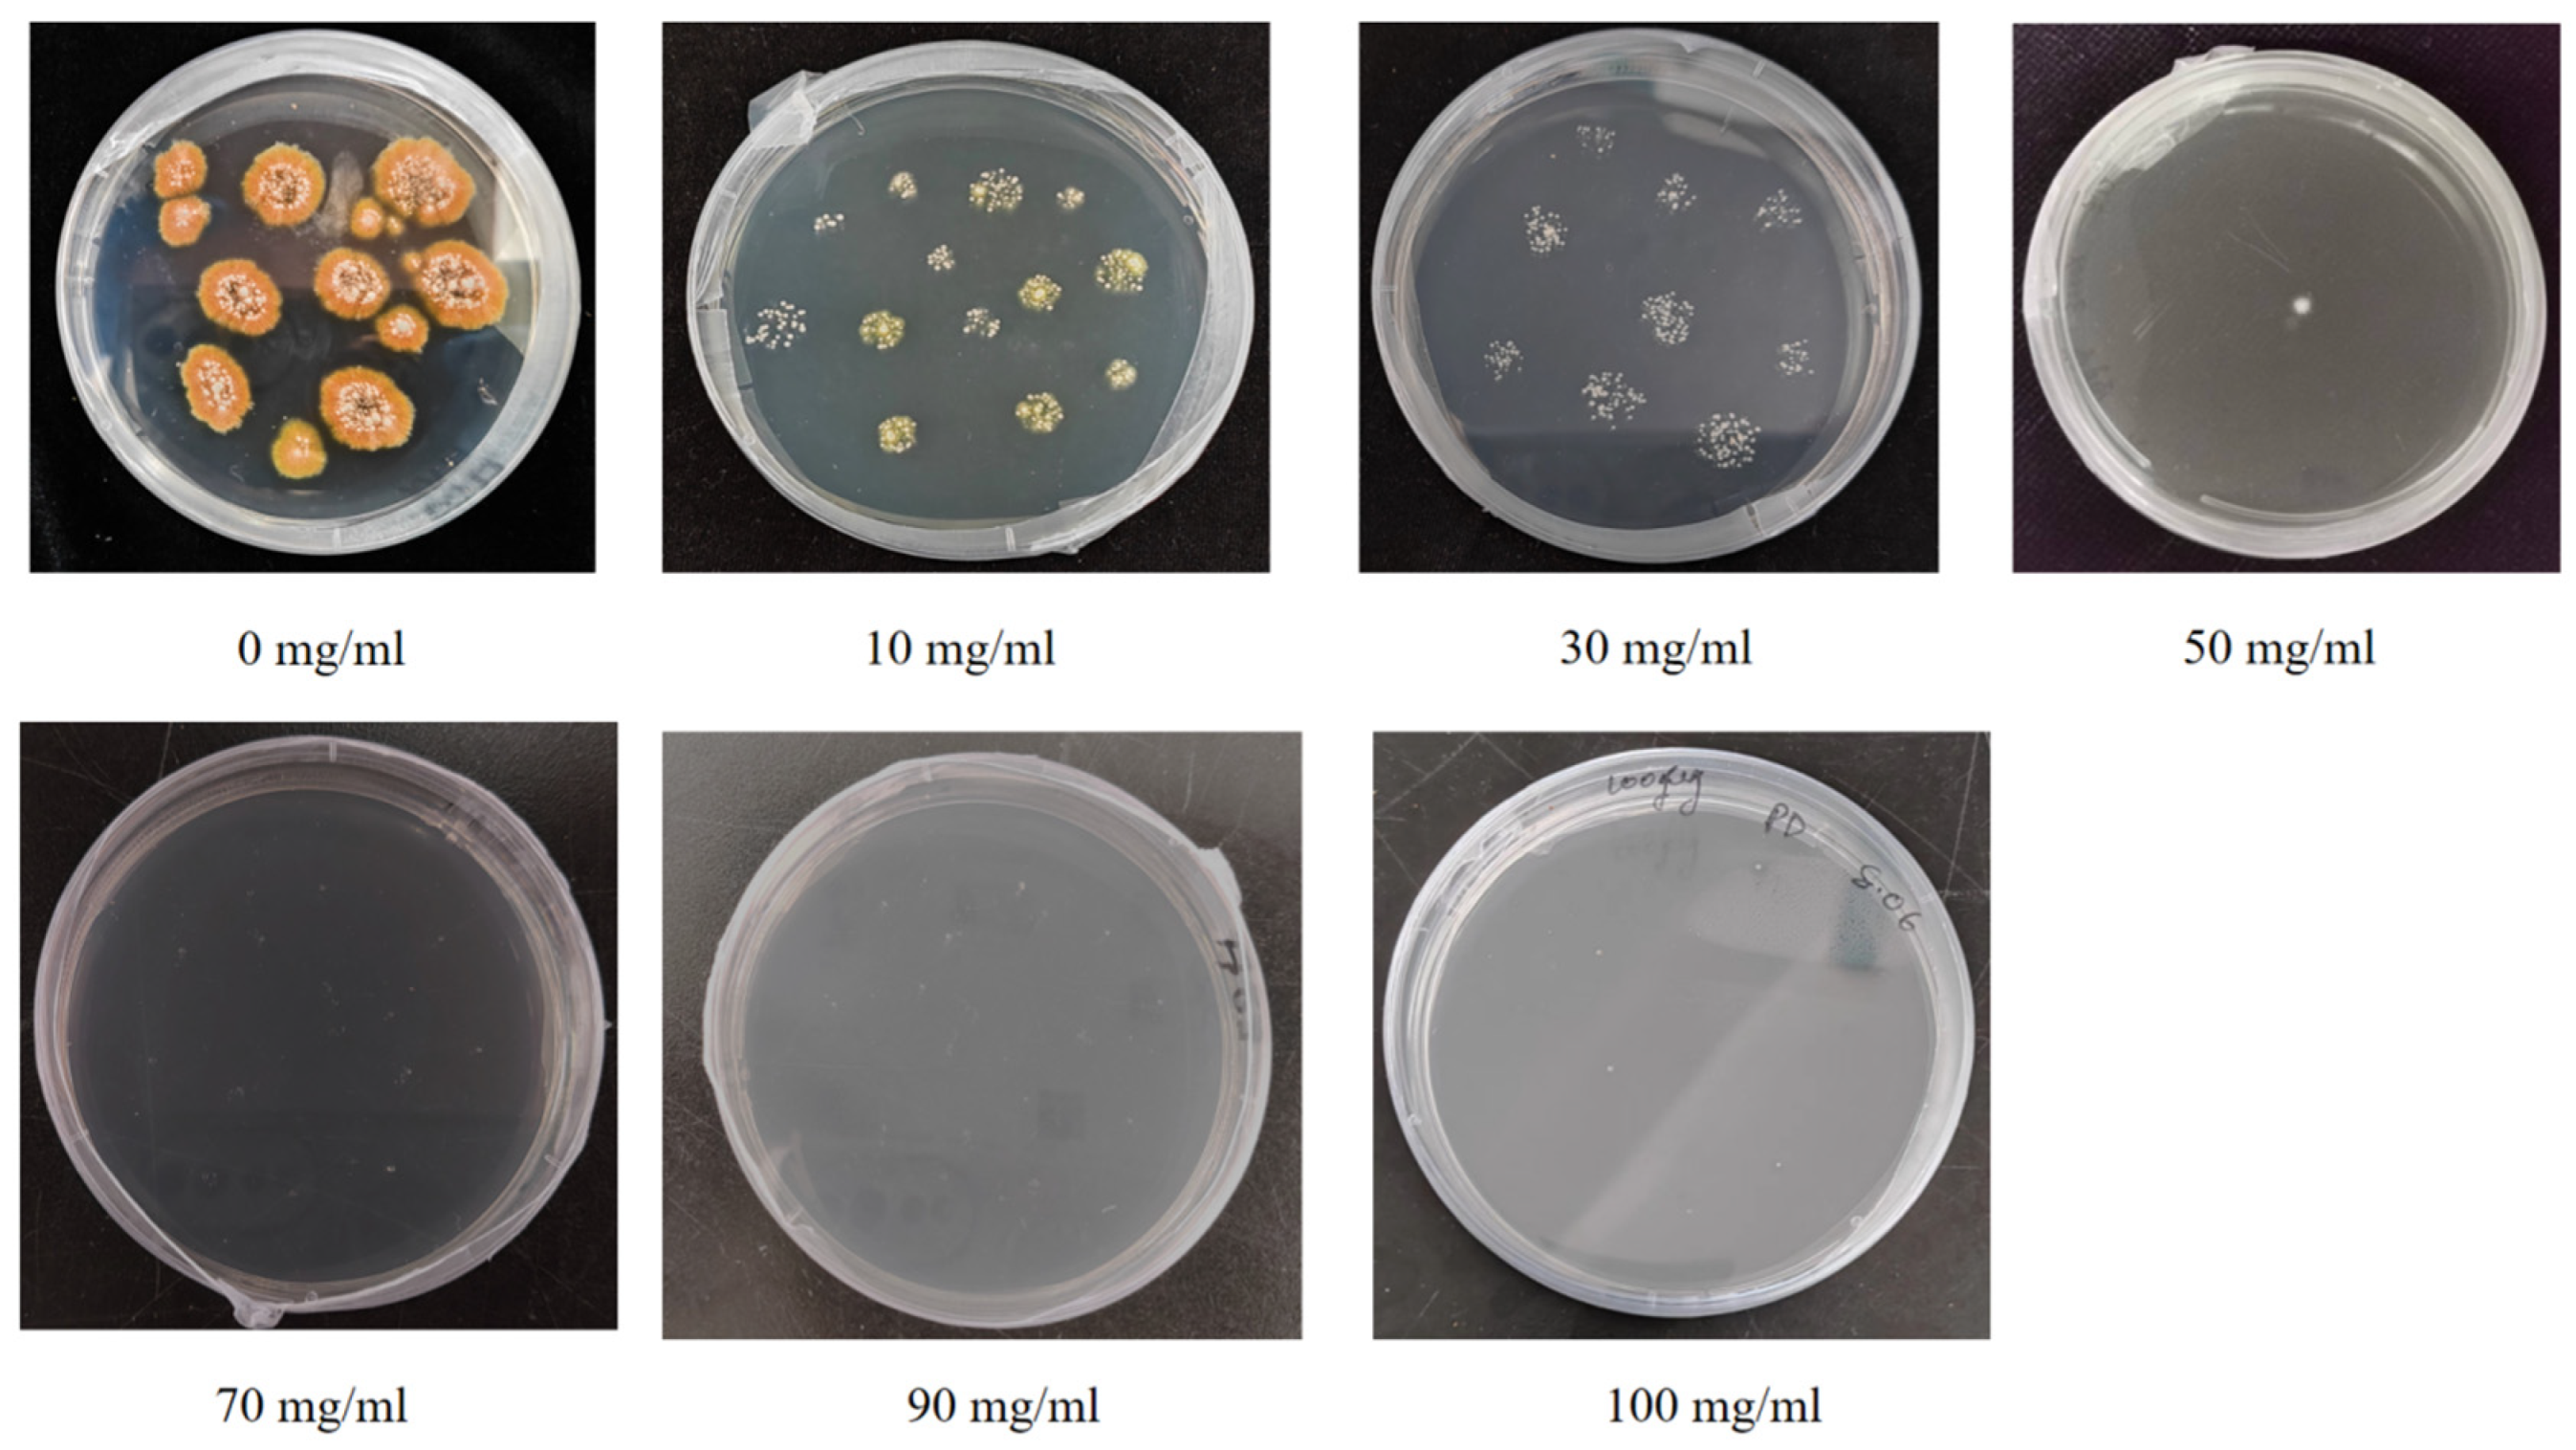
Jof 11 00386 g003 Jof 11 00386 g003

PEG-Mediated Protoplast Transformation of Penicillium sclerotiorum (scaumcx01): Metabolomic Shifts and Root Colonization Dynamics
Abstract
1. Introduction
2. Materials and Methods
2.1. Media Culture
2.2. Fungal Strain and Plasmid Vector
2.3. Protoplast Generation
2.3.1. Hyphal Preparation
2.3.2. Enzymatic Digestion for Protoplast
2.3.3. Protoplast Yield Optimization
2.3.4. Osmotic Stabilizer Test
2.3.5. Protoplast Regeneration and Viability Assessment
2.3.6. Screening of Strain scaumcx01 Resistance to Hygromycin Resistance Gene
2.4. Genetic Transformation of Strain scaumcx01 Protoplasts
2.4.1. Fluorescence Intensity Detection of Strain scaumcx01 Transformants
2.4.2. Assessment of the Transformants
2.4.3. Confirmation of GFP Presence and Localization
2.5. Metabolomic Analysis of Wild-Type and GFP-Tagged scaumcx01
2.5.1. UPLC-HRMS Detection for Preparation of Test Solution
2.5.2. Liquid Phase Mass Spectrometry Conditions
2.6. Enzymatic Pre-Treatment of Tomato Roots for Fungal Colonization Analysis
Confocal Microscopy Imaging for Root
2.7. Statistical Analyse
3. Results
3.1. P. sclerotiorum-scaumcx01 Protoplast Isolation
3.2. Effect of Enzyme Combination on Protoplast Preparation
3.3. Osmotic Stabilizer and Other Factors on Protoplast Preparation
3.4. Protoplast Regeneration
3.5. PEG-Mediated GFP Transformation and Selection of P. sclerotiorum-scaumcx01
Stability and Fluorescence Localization of GFP-Tagged scaumcx01
3.6. Metabolomic Analysis of GFP Tagged Strain scaumcx01
3.7. Colonization of Tomato Roots by GFP-Labeled Strain scaumcx01
4. Discussion
5. Conclusions
Supplementary Materials
Author Contributions
Funding
Institutional Review Board Statement
Informed Consent Statement
Data Availability Statement
Conflicts of Interest
References
- Arora Singh, D.; Chandra, P.; Jeet Kaur, G. Optimization and assay of antioxidant potential of two Penicillium spp. by different procedures. Curr. Biotechnol. 2012, 1, 2–10. [Google Scholar] [CrossRef]
- Chen, S.; Cai, R.; Liu, Z.; Cui, H.; She, Z. Secondary metabolites from mangrove-associated fungi: Source, chemistry and bioactivities. Nat. Prod. Rep. 2022, 39, 560–595. [Google Scholar] [CrossRef] [PubMed]
- Zeng, Y.; Wang, Z.; Chang, W.; Zhao, W.; Wang, H.; Chen, H.; Dai, H.; Lv, F. New azaphilones from the marine-derived fungus Penicillium sclerotiorum E23Y-1A with their anti-inflammatory and antitumor activities. Mar. Drugs 2023, 21, 75. [Google Scholar] [CrossRef]
- Jahan, I.; Wang, Y.; Li, P.; Hussain, S.; Song, J.; Yan, J. Comprehensive Analysis of Penicillium sclerotiorum: Biology, Secondary Metabolites, and Bioactive Compound Potential—A Review. J. Agric. Food Chem. 2024, 72, 9555–9566. [Google Scholar] [CrossRef]
- Olmedo-Monfil, V.; Cortés-Penagos, C.; Herrera-Estrella, A. Three decades of fungal transformation: Key concepts and applications. In Recombinant Gene Expression: Reviews and Protocols; Humana Press International: Totowa, NJ, USA, 2004; pp. 315–325. [Google Scholar]
- Bachmann, B.J.; Bonner, D.M. Protoplasts from Neurospora Crassa. J. Bacteriol. 1959, 78, 550–556. [Google Scholar] [CrossRef]
- Eddy, A.A. The probable nuclear origin of certain of the bodies released from yeast protoplasts by ultrasonic treatment. Exp. Cell Res. 1959, 17, 447–464. [Google Scholar] [CrossRef]
- Anne, J. Protoplasts of filamentous fungi in genetics and metabolite production. In Protoplasts 1983: Lecture Proceedings; Birkhauser Verlag: Basel, Switzerland; Stuttgart, Germany; New York, NY, USA, 1983; pp. 167–178. [Google Scholar]
- Lalithakumari, D. Fungal Protoplast: A Biotechnological Tool; CRC Press: Boca Raton, FL, USA, 2019. [Google Scholar]
- Zhao, X.Q.; Zhang, X.Y.; Zhang, F.; Zhang, R.; Jiang, B.J.; Bai, F.W. Metabolic engineering of fungal strains for efficient production of cellulolytic enzymes. In Fungal Cellulolytic Enzymes: Microbial Production and Application; Springer: Singapore, 2018; pp. 27–41. [Google Scholar]
- Li, W.; Zou, G.; Bao, D.; Wu, Y. Current Advances in the Functional Genes of Edible and Medicinal Fungi: Research Techniques, Functional Analysis, and Prospects. J. Fungi 2024, 10, 311. [Google Scholar] [CrossRef]
- Varavallo, M.A.; de Queiroz, M.V.; Pereira, J.F.; de Araújo, E.F. Isolation and regeneration of Penicillium brevicompactum protoplasts. Acta Sci. 2004, 26, 475–479. [Google Scholar]
- Li, D.; Tang, Y.; Lin, J.; Cai, W. Methods for genetic transformation of filamentous fungi. Microb. Cell Factories 2017, 16, 1–13. [Google Scholar] [CrossRef]
- Peberdy, J.F. Fungal protoplasts. In More Gene Manipulations in Fungi; Academic Press: New York, NY, USA, 1991; pp. 307–318. [Google Scholar]
- Garcia-Rubio, R.; de Oliveira, H.C.; Rivera, J.; Trevijano-Contador, N. The fungal cell wall: Candida, Cryptococcus, and Aspergillus species. Front. Microbiol. 2020, 10, 492056. [Google Scholar] [CrossRef]
- Kollerov, V.; Donova, M. Ursodeoxycholic acid production by Gibberella zeae mutants. AMB Express 2022, 12, 105. [Google Scholar] [CrossRef] [PubMed]
- Wu, J.D.; Chou, J.C. Optimization of protoplast preparation and regeneration of a medicinal fungus Antrodia cinnamomea. Mycobiology 2019, 47, 483–493. [Google Scholar] [CrossRef] [PubMed]
- Liu, Z.; Friesen, T.L. Polyethylene glycol (PEG)-mediated transformation in filamentous fungal pathogens. In Plant Fungal Pathogens: Methods and Protocols; Humana Press: Totowa NJ, USA, 2012; pp. 365–375. [Google Scholar]
- Bartsch, S.; Schimek, C.; Wöstemeyer, J. Microprojectile bombardment as a reliable method for transformation of the mucoralean fungus Absidia glauca. Mycoscience 2002, 43, 0213–0217. [Google Scholar] [CrossRef]
- Rolland, S.; Jobic, C.; Fèvre, M.; Bruel, C. Agrobacterium-mediated transformation of Botrytis cinerea, simple purification of monokaryotic transformants and rapid conidia-based identification of the transfer-DNA host genomic DNA flanking sequences. Curr. Genet. 2003, 44, 164–171. [Google Scholar] [CrossRef]
- Buron-Moles, G.; Lopez-Perez, M.; Gonzalez-Candelas, L.; Viñas, I.; Teixido, N.; Usall, J.; Torres, R. Use of GFP-tagged strains of Penicillium digitatum and Penicillium expansum to study host-pathogen interactions in oranges and apples. Int. J. Food Microbiol. 2012, 160, 162–170. [Google Scholar] [CrossRef]
- Arie, T.; Takahashi, H.; Kodama, M.; Teraoka, T. Tomato as a model plant for plant-pathogen interactions. Plant Biotechnol. 2007, 24, 135–147. [Google Scholar] [CrossRef]
- Tian, X.F.; Fang, Z.; Guo, F. Impact and prospective of fungal pre-treatment of lignocellulosic biomass for enzymatic hydrolysis. Biofuels Bioprod. Biorefining 2012, 6, 335–350. [Google Scholar] [CrossRef]
- Tiwari, P.K.; Yadav, J.; Singh, A.K.; Srivastava, R.; Srivastava, A.K.; Sahu, P.K.; Srivastava, A.K.; Saxena, A.K. Architectural analysis of root system and phytohormone biosynthetic genes expression in wheat (Triticum aestivum L.) inoculated with Penicillium oxalicum. Lett. Appl. Microbiol. 2022, 75, 1596–1606. [Google Scholar] [CrossRef]
- Gu, K.; Chen, C.Y.; Selvaraj, P.; Pavagadhi, S.; Yeap, Y.T.; Swarup, S.; Zheng, W.; Naqvi, N.I. Penicillium citrinum provides transkingdom growth benefits in choy sum (Brassica rapa var. parachinensis). J. Fungi 2023, 9, 420. [Google Scholar] [CrossRef]
- Gómez-Muñoz, B.; Jensen, L.S.; De Neergaard, A.; Richardson, A.E.; Magid, J. Effects of Penicillium bilaii on maize growth are mediated by available phosphorus. Plant Soil 2018, 431, 159–173. [Google Scholar] [CrossRef]
- Lorang, J.M.; Tuori, R.P.; Martinez, J.P.; Sawyer, T.L.; Redman, R.S.; Rollins, J.A.; Wolpert, T.J.; Johnson, K.B.; Rodriguez, R.J.; Dickman, M.B.; et al. Green fluorescent protein is lighting up fungal biology. Appl. Environ. Microbiol. 2001, 67, 1987–1994. [Google Scholar] [CrossRef] [PubMed]
- Andrie, R.M.; Martinez, J.P.; Ciuffetti, L.M. Development of ToxA and ToxB promoter-driven fluorescent protein expression vectors for use in filamentous ascomycetes. Mycologia 2005, 97, 1152–1161. [Google Scholar] [CrossRef] [PubMed]
- Li, L.; Yin, Q.; Liu, X.; Yang, H. An efficient protoplast isolation and regeneration system in Coprinus comatus. Afr. J. Microbiol. Res. 2010, 4, 459–465. [Google Scholar]
- Möller, E.M.; De Cock AW, A.M.; Prell, H.H. Mitochondrial and nuclear DNA restriction enzyme analysis of the closely related Phytophthora species P. infestans, P. mirabilis, and P. phaseoli. J. Phytopathol. 1993, 139, 309–321. [Google Scholar] [CrossRef]
- Bajaj, Y.P.S. Plant Protoplasts and Genetic Engineering II; Springer Science & Business Media: Berlin/Heidelberg, Germany, 2012; Volume 9. [Google Scholar]
- Alshahni, M.M.; Yamada, T. Genetic manipulations in dermatophytes. Mycopathologia 2017, 182, 33–43. [Google Scholar] [CrossRef]
- Ning, Y.; Hu, B.; Yu, H.; Liu, X.; Jiao, B.; Lu, X. Optimization of protoplast preparation and establishment of genetic transformation system of an arctic-derived fungus Eutypella sp. Front. Microbiol. 2022, 13, 769008. [Google Scholar] [CrossRef]
- Jin, L.Q.; Xu, Z.W.; Men, X.H.; Zhang, B.; Zheng, Y.G. Enhancement of protoplast preparation and regeneration of Hirsutella sinensis based on process optimization. Biotechnol. Lett. 2020, 42, 2357–2366. [Google Scholar] [CrossRef]
- Cheng, Y.; Bélanger, R.R. Protoplast preparation and regeneration from spores of the biocontrol fungus Pseudozyma flocculosa. FEMS Microbiol. Lett. 2000, 190, 287–291. [Google Scholar] [CrossRef][Green Version]
- Marcone, G.L.; Carrano, L.; Marinelli, F.; Beltrametti, F. Protoplast preparation and reversion to the normal filamentous growth in antibiotic-producing uncommon actinomycetes. J. Antibiot. 2010, 63, 83–88. [Google Scholar] [CrossRef]
- Wang, Q.; Yu, G.; Chen, Z.; Han, J.; Hu, Y.; Wang, K. Optimization of protoplast isolation, transformation and its application in sugarcane (Saccharum spontaneum L). Crop J. 2022, 9, 133–142. [Google Scholar] [CrossRef]
- Schwerdt, J.; Qiu, H.; Shirley, N.; Little, A.; Bulone, V. Phylogenomic analyses of nucleotide-sugar biosynthetic and interconverting enzymes illuminate cell wall composition in fungi. Mbio 2021, 12, e03540-20. [Google Scholar] [CrossRef] [PubMed]
- Amalamol, D.; Ashwin, N.M.R.; Lakshana, K.V.; Nirmal Bharathi, M.; Ramesh Sundar, A.; Sukumaran, R.K.; Malathi, P.; Viswanathan, R. A highly efficient stratagem for protoplast isolation and genetic transformation in filamentous fungus Colletotrichum falcatum. Folia Microbiol. 2022, 67, 479–490. [Google Scholar] [CrossRef] [PubMed]
- Matsuzaki, M.; Tatsumi, R.; Kita, K. Protoplast generation from the ascofuranone-producing fungus Acremonium sclerotigenum. Cytologia 2017, 82, 317–320. [Google Scholar] [CrossRef]
- Varavallo, M.A.; Queiroz, M.V.D.; Lana, T.G.; Brito, A.T.R.D.; Gonçalves, D.B.; Araújo, E.F.D. Isolation of recombinant strains with enhanced pectinase production by protoplast fusion between Penicillium expansum and Penicillium griseoroseum. Braz. J. Microbiol. 2007, 38, 52–57. [Google Scholar] [CrossRef]
- Shin, J.H.; Han, J.H.; Park, H.H.; Fu, T.; Kim, K.S. Optimization of polyethylene glycol-mediated transformation of the pepper anthracnose pathogen Colletotrichum scovillei to develop an applied genomics approach. Plant Pathol. J. 2019, 35, 575–584. [Google Scholar] [CrossRef]
- Chung, K.C.; Park, C.R. Formation and Regeneration of Penicillium verruculosum Protoplasts. Microbiol. Biotechnol. Lett. 1988, 16, 156–162. [Google Scholar]
- Ai-Huan, S.; Hong-Ye, L.; Xiao-Hong, L. Isolation and regeneration of protoplasts from Penicillium digitatum. Chin. J. Agric. Biotechnol. 2004, 1, 197–202. [Google Scholar] [CrossRef]
- Lim, F.H.; Rasid, O.A.; Idris, A.S.; As’ wad, A.W.M.; Vadamalai, G.; Parveez, G.K.A.; Wong, M.Y. Enhanced polyethylene glycol (PEG)–mediated protoplast transformation system for the phytopathogenic fungus, Ganoderma boninense. Folia Microbiol. 2021, 66, 677–688. [Google Scholar] [CrossRef]
- Tripathi, A.; Shukla, S. Methods of genetic transformation: Major emphasis to crop plants. J. Microbiol. Biotechnol. Food Sci. 2024, 13, e10276. [Google Scholar]
- De Silva, A.P.; Bolton, M.D.; Nelson, B.D. Transformation of Sclerotinia sclerotiorum with the green fluorescent protein gene and fluorescence of hyphae in four inoculated hosts. Plant Pathol. 2009, 58, 487–496. [Google Scholar] [CrossRef]
- Dubey, M.K.; Ubhayasekera, W.; Sandgren, M.; Funck Jensen, D.; Karlsson, M. Disruption of the Eng18B ENGase gene in the fungal biocontrol agent Trichoderma atroviride affects growth, conidiation and antagonistic ability. PLoS ONE 2012, 7, e36152. [Google Scholar] [CrossRef]
- Kiheri, H.; Velmala, S.; Pennanen, T.; Timonen, S.; Sietiö, O.M.; Fritze, H.; Heinonsalo, J.; van Dijk, N.; Dise, N.; Larmola, T. Fungal colonization patterns and enzymatic activities of peatland ericaceous plants following long-term nutrient addition. Soil Biol. Biochem. 2020, 147, 107833. [Google Scholar] [CrossRef]
- Panicker, S.; Sayyed, R.Z. Hydrolytic enzymes from PGPR against plant fungal pathogens. In Antifungal Metabolites of Rhizobacteria for Sustainable Agriculture; Springer International Publishing: Cham, Switzerland, 2022; pp. 211–238. [Google Scholar]

| Target Gene | Sequence (5′–3′) | Amplicon Size (bp) |
|---|---|---|
| GFP | GCGACGTAAACGGCCACAAG (Forward) CCAGCAGGACCATGTGTGATCG (Reverse) | 720 |
| hygR | ATGAAAAAGCCTGAACTCACCGCGACGT (Forward) CGACGCCCCAGCACTCGTCCGAGGGCAA (Reverse) | 1020 |
| Fungal ITS region | GAGACGAGTTGGCAGCAGGAATAG (Forward) CCTCGCCCTTCTTGTGACTTTGG (Reverse) | 140 |
Disclaimer/Publisher’s Note: The statements, opinions and data contained in all publications are solely those of the individual author(s) and contributor(s) and not of MDPI and/or the editor(s). MDPI and/or the editor(s) disclaim responsibility for any injury to people or property resulting from any ideas, methods, instructions or products referred to in the content. |
© 2025 by the authors. Licensee MDPI, Basel, Switzerland. This article is an open access article distributed under the terms and conditions of the Creative Commons Attribution (CC BY) license (https://creativecommons.org/licenses/by/4.0/).
Share and Cite
Jahan, I.; Yang, Q.; Guan, Z.; Wang, Y.; Li, P.; Jian, Y. PEG-Mediated Protoplast Transformation of Penicillium sclerotiorum (scaumcx01): Metabolomic Shifts and Root Colonization Dynamics. J. Fungi 2025, 11, 386. https://doi.org/10.3390/jof11050386
Jahan I, Yang Q, Guan Z, Wang Y, Li P, Jian Y. PEG-Mediated Protoplast Transformation of Penicillium sclerotiorum (scaumcx01): Metabolomic Shifts and Root Colonization Dynamics. Journal of Fungi. 2025; 11(5):386. https://doi.org/10.3390/jof11050386
Chicago/Turabian StyleJahan, Israt, Qilin Yang, Zijun Guan, Yihan Wang, Ping Li, and Yan Jian. 2025. "PEG-Mediated Protoplast Transformation of Penicillium sclerotiorum (scaumcx01): Metabolomic Shifts and Root Colonization Dynamics" Journal of Fungi 11, no. 5: 386. https://doi.org/10.3390/jof11050386
APA StyleJahan, I., Yang, Q., Guan, Z., Wang, Y., Li, P., & Jian, Y. (2025). PEG-Mediated Protoplast Transformation of Penicillium sclerotiorum (scaumcx01): Metabolomic Shifts and Root Colonization Dynamics. Journal of Fungi, 11(5), 386. https://doi.org/10.3390/jof11050386






